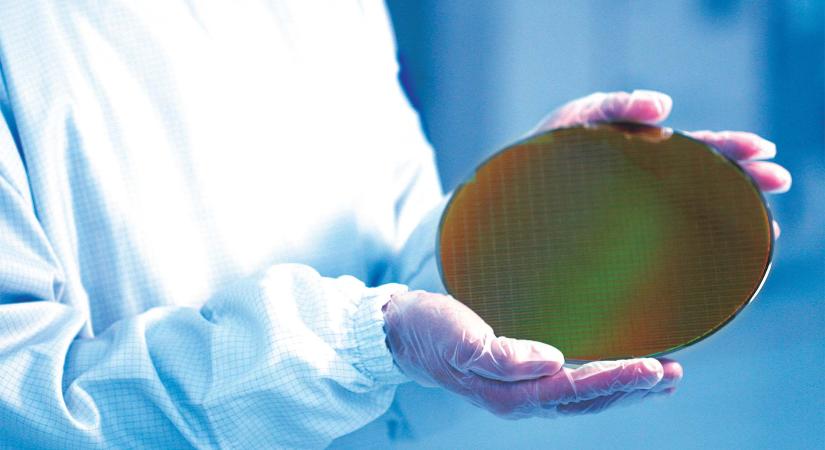
A Qualcomm is benevezhet a Samsung 2 nm-es gyártására

A Qualcomm is benevezhet a Samsung 2 nm-es gyártására
Egyre biztosabb, hogy látni fogunk a jövőben olyan Snapdragon lapkát, ami a Samsung eddigi legjobb gyártási eljárását alkalmazza.

Hamarosan átirányítunk a teljes cikkhez → iPON!
Egyre biztosabb, hogy látni fogunk a jövőben olyan Snapdragon lapkát, ami a Samsung eddigi legjobb gyártási eljárását alkalmazza.
Hamarosan átirányítunk a teljes cikkhez → iPON!